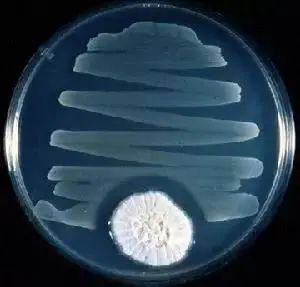

菜市场里的一颗发霉哈密瓜,竟然藏着千万人的“救命稻草”......
英国伦敦,圣玛丽医院(St. Mary's Hospital, London)。这里藏着一个微小的房间,用来纪念医学史上最重要的发现之一:一种改变了世界、挽救了数百万人生命的霉菌。
 伦敦圣玛丽医院中的弗莱明实验室博物馆。| 图源:St. Mary's Hospital, London
伦敦圣玛丽医院中的弗莱明实验室博物馆。| 图源:St. Mary's Hospital, London为了纪念亚历山大·弗莱明(Alexander Fleming)及其对青霉素发现的历史贡献,后人在弗莱明发现青霉素时的圣玛丽医院,建立了一个小型博物馆,重现了弗莱明在 1928 年发现青霉素时的实验室,包括他的显微镜、培养皿以及其他实验设备,甚至还复刻了他工作时不离手的香烟。
世界各地的收藏馆都保存着弗莱明原始分离物(被命名为 Penicillium rubens IMI 15378)的冷冻样本,但今天的青霉素生产使用的并不是他发现的这一菌株。实际上,撑起了现如今数十亿美元青霉素生产产业的菌株,来源于 1940 年代初期美国伊利诺伊州皮奥里亚一个菜市场里的一颗发霉哈密瓜。
就像很多我们习以为常但又不可或缺的东西(比如 X 射线、微波炉)实际上都来源于偶然的发现一样:青霉素的发现,同样来自巧合,应该说它是科学史上最著名的偶然发现之一。更神奇的是,从首次发现青霉素开始,随后的每一步重大发展似乎都充满了奇遇。传记作家格温·麦克法兰(Gwyn Macfarlane)形容这一过程为“一连串几乎难以置信的偶然事件。” 在抗生素出现之前,即使是最小的割伤对人类来说也可能是致命的。青霉素的发现和量产,不仅立即挽救了二战末期无数士兵的生命,使他们免于死于感染,还产生了长远的影响,至今其影响依然存在。
抗生素:前传
在古时候,无论中外,超出人类理解和掌控范围的现象,多被解读成“神灵的惩罚”,或者是“魔鬼的诅咒”。在抗生素被发现之前,微生物导致的感染就是这样一种存在。作为千百年来人类发病和死亡的主要原因之一,“感染”曾经远比现如今我们所惧怕的癌症更加令人闻风丧胆。
人们通常认为,青霉素是人类历史上第一次发现并应用的抗生素,事实上并不是。人类尝试利用微生物来“以毒攻毒”治疗感染性疾病,早在前千百年前的塞尔维亚、中国、古希腊和古埃及等地就有记载。古埃及的《埃伯斯纸草文稿》(Eber’s papyrus,约公元前 1550 年)中就描述了用发霉的面包和土壤来治疗感染的方法。同样,在埃及达赫莱绿洲发现的人类骨骼中,也检测出四环素的痕迹,表明古人类可能通过某种方式摄取了这种天然抗生素。
在现代历史中,第一个用现代科学的方法从自然界中成功提取的抗生素也不是青霉素,而是霉酚酸(Mycophenolic Acid)。1893 年,意大利医生、微生物学家巴托洛梅奥·戈西奥(Bartolomeo Gosio)在研究糙皮病(Pellagra)时,从绿色青霉菌(Penicillium glaucum,现称短密青霉菌 (P. brevicompactum))中分离出这种结晶固体抗生素。当时的研究表明,霉酚酸不光能够抑制炭疽杆菌(Bacillus anthracis)的生长,还兼具抗病毒、抗真菌、抗肿瘤和抗银屑病等多种特性。
人们通常会牢牢记住并歌颂各种“第一次”,那为什么青霉素以及其发现者弗莱明并非第一,还能获诺贝尔奖,被写进教科书,被各国人民传颂至今呢?
一方面,青霉素虽不是第一,却是应用最广泛的、在世界上造成的影响最大、最深远,挽救生命最多的抗生素;另一方面,青霉素发现和应用的这段历史,有着不可替代的“故事性”:有战争、政治、资本,也有科学、人文和伦理;有新药救人的辉煌,也有医学尽头的无奈。整个故事,以科学家的灵光一现为起点,被一连串跌宕起伏的巧合所贯穿。这样的情节,如果有一位愿意牺牲自己头发的编剧和一众靠谱的演员,一定可以拍成跟《奥本海默》一样的大片。
青霉素发现的第一个巧合:
污染的细菌培养皿
1928 年 9 月平平无奇的一天,佛系做实验的亚历山大·弗莱明刚结束两周的休假回到实验室,突然发现由于疏于打理,自己养的一盘细菌里出现了大大小小的霉菌,通俗来说,实验品长毛儿了。他本来想顺手扔掉,但不经意间瞥见,在其中一大团霉菌周围,出现了一圈规整的“透明地带”,而这一圈透明带以外,细菌长得好好的。也就是说,这一圈透明带范围内的细菌,似乎发生了裂解死亡。
弗莱明于 1929 年在《英国实验病理学杂志》(British Journal of Experimental Pathology)上发表的一篇论文中写道:“葡萄球菌的菌落变得透明,并显然正在裂解……经室温培养 1 到 2 周后,该霉菌的肉汤培养液对多种常见致病菌展现出显著的抑菌活性,同时具有杀菌及溶菌作用。”
细菌培养板上的一团霉菌和周围的“细菌死亡带”。| 图源:网络
细菌培养板上的一团霉菌和周围的“细菌死亡带”。| 图源:网络为什么呢?
弗莱明认为,这团霉菌可能产生了一种对细菌致命的物质。通过品种鉴定,他确定这种霉菌是一种青霉菌(Penicillium notatum),并首次将它所分泌的这种能杀死细菌的物质命名为“青霉素”。是不是真菌都有这种能力呢?弗莱明很快尝试培养了几种其他的霉菌,看看它们是否也能对细菌产生相同的效果,但结果证明,只有碰巧污染了自己的实验对象的那种青霉菌有这种能力。
每一项改变世界的科学进展在刚提出的时候似乎都是超越时代认知的,也因此多不被人认可。弗莱明在 1929 年发表的青霉素研究论文在当时并未引起多大关注,他在伦敦医学研究俱乐部(Medical Research Club)激动地向人们介绍这项研究,然而甚至没有一位听众提出问题。
虽然实验显示青霉素有抗菌效果,弗莱明也观察并详细记录了霉菌对细菌的作用,但是如果不把培养皿中的青霉素分离出来,就无法真正验证其作用,青霉素的“神迹”就永远只能停留在笔记和论文中。在接下来的几年中,弗莱明想尽办法,始终无法成功分离出这种抗菌物质。青霉素的提纯研究似乎碰到了一堵无法越过的墙。
弗莱明并没有闭门造车,孤军奋战。他找过领域内的其他著名学者帮助,但是大家在尝试之后也都中断了研究。究其原因,学界虽然承认青霉素在实验中的抗菌作用是真实的,但是由于青霉素似乎是“不稳定的”,无法大量的提纯,无法量产,也就永远无法在临床医学中得到实际应用。
很可惜,弗莱明再三努力,并未能成功纯化青霉素。1931 年,他不得已中断了对青霉素的研究,但是还保留了最后一丝希望。他昭告天下:任何人如果想再尝试分离青霉素,自己都可以免费提供霉菌样本。
 弗莱明在培养细菌。| 图源:TheScientist.com
弗莱明在培养细菌。| 图源:TheScientist.com青霉素发现的第二个巧合:
从“垃圾箱”里捡回的论文
从那以后的十年,青霉素的研究论文被学界放进了“垃圾桶”,几乎无人问津。
许久以来,在牛津大学工作的霍华德·弗洛里(Howard Florey)研究兴趣集中在对细菌和霉菌之间的关系上。1938 年,他随意翻阅领域内的文献时,偶然翻到了弗莱明 10 年前发表在《英国实验病理学杂志》上那篇关于青霉菌的论文。像触电一样,他觉得这篇论文里的内容藏着等待发掘的巨大潜力。与他的两个助手恩斯特·查恩(Ernst Chain)和诺曼·希特利(Norman Heatley)一起,他们共同揭开了青霉素研究的历史尘封,开始研究青霉菌的生长条件,并初步分离出了少量的青霉素。
通过动物实验,他们首次发现青霉素能够有效杀死小鼠体内的细菌感染,而且几乎没有什么副作用。到 1940 年,牛津的研究团队已经成功确定了青霉菌的最佳培养条件,提纯了青霉素,并证明它可以让小鼠免于三种致命细菌感染的侵害。
 弗洛里(后排左二)、查恩(后排右二)和牛津青霉素团队成员。丨图源:wiki
弗洛里(后排左二)、查恩(后排右二)和牛津青霉素团队成员。丨图源:wiki动物试验的成功,使他们迫切希望开展人体临床试验。恰好弗洛里等人听说在牛津一家医院里有一位因金黄色葡萄球菌(Staphylococcus aureus)感染住院的病人,已引发了败血症,病入膏肓。死马当活马医,他们决定让他接受青霉素的实验性治疗,因此这位病人成为青霉素治疗第一人。他的名字叫作阿尔伯特·亚历山大(Albert Alexander)。
1941 年 2 月 12 日,研究人员首次给亚历山大以青霉素治疗。有如神助,仅用了不到一天,病人的状况就有了显著改善,并且没有发现副作用!然而不幸的是,治疗全身感染所需的青霉素理论剂量,等同于培养整整 2000 升的青霉菌。当为数不多的青霉素存货耗尽后,病菌卷土重来,感染加重,亚历山大也不幸去世。(作为第一位接受青霉素治疗的人,亚历山大同样常出现在青霉素历史发现的讲述中,然而关于他的故事也同样包含误解。长期以来,资料都说他的感染是由于被花园中玫瑰的棘刺划伤,但事实上,是因为警局遭到了轰炸,他被弹片划伤从而引发了感染。)
虽然青霉素在这个案例中并没有完全成功,但青霉素所具有的巨大潜力无疑已经亮出了冰山一角。不过,就算这个案例成功,靠个别情况也完全不能说服医学界。为了证实早期试验的成果,更大规模的药物临床试验势在必行。而大规模的试验,意味着巨量的青霉素需求。研究人员意识到,如果无法找到大规模生产这种几乎神奇的物质的方法,青霉素的疗效永远只是纸上谈兵。
在当时,英国整个化学工业要不就是已经被二战破坏,要不就是完全服务于战争的生产需求,在英国大规模生产青霉素这条路根本行不通,弗洛里不得不把眼光望向国外。几经周折,在洛克菲勒基金会的支持下,弗洛里和希特利于 1941 年夏天——美国参加二战的前夕,远渡重洋,想看看是否能够在美国延续这个未竟的事业。
这场跨越大西洋的合作,确实成为了青霉素从实验室走向战场,最终改变全球医学的重要转折点。
青霉素发现的第三个巧合:
皮奥里亚市场上的烂哈密瓜
从在培养皿中发现青霉素,到有能力把青霉素提纯出足够的量来用于尝试治病,就是这么听起来易如反掌的一步,科学家们用了十多年的时间。
弗洛里和希特利在学界的朋友们辗转把他们介绍到了一个在发酵领域有一定技术积累的实验室,也就是美国伊利诺伊州皮奥里亚的农业部北方区域研究实验室(Northern Regional Research Laboratory,NRRL)。搭上了这一条线,对于后续的成功是决定性的。
在实验室主任奥维尔·梅(Orville May)的牵头下,希特利留在了美国,跟实验团队共同攻关。正所谓术业有专攻,在短短几周内,团队通过在培养基中用乳糖代替蔗糖,向发酵培养基中添加玉米浆液,以及添加青霉素前体(如苯乙酸)等方法,迅速提高了青霉素的产量。
但是研究组仍不满意,在培养基表面上培养霉菌的方法仍然效率低下,如果能把“表面培养”变成“浸没式培养”,即将菌体(如青霉菌)完全浸泡在液体培养基中进行培养,就能更充分地利用培养基里的物质,让青霉素产量实现“指数级”增加。换而言之,从“二维培养”变成“三维培养”,实现“升维打击”。可惜,来自英国的青霉菌种在浸没式培养中“水土不服”,产量更差,只能产生微量的青霉素。
再三讨论下,研究人员的主攻方向从“换技术”变成了“换菌种”。
不同菌株的特性和产量是不同的,实验室筛选了各种青霉菌菌株的存货,确实找到了一种在浸没式培养中产量还可以的青霉素菌株。但研究组还不满足:世界那么大,有没有可能最完美的青霉菌株隐藏在某个不为人知的角落?于是,实验室开始想办法借助更多人的力量,在全球范围内发起了“寻找高产青霉素菌株”的搜索行动,并寻求军方帮忙运输。很快,来自世界各地的样本被源源不断地送来,用以分离霉菌。
这时,在青霉素的发现和应用历史中最大的巧合来了,而且颇具讽刺意味:他们从实验室附近的农贸市场里一颗长毛的哈密瓜上,分离出了最佳菌株(NRRL 1951)。
就是在这颗烂瓜上的菌株(Penicillium chrysogenum,中译名为产黄青霉),其青霉素产量是弗莱明当时发现的菌株的整整 200 倍。通过 X 线照射诱发菌株的基因突变,他们最终获得了有着初始菌株 1000 倍产量的“超级青霉”。
希特利和他的研究者朋友们再聪明,也想象不到,大家苦苦寻觅的“宝贝”菌株,并不是远在天边,而是近在眼前,就在这个看似以巧合为起点的研究合作实验室所在的美国城市。城市中农贸市场的这个发霉的烂瓜,藏着千万人的“救命稻草”。
那么,究竟是谁发现了这棵烂瓜呢?发现者理应也是这段传奇偶然故事中的一员,最初当地报纸的报道是 NRRL 女技术员玛丽·亨特(Mary Hunt),还被冠以绰号“Moldy Mary”,即发霉的玛丽。
后来她在1962年的一篇文章中还讲述了自己如何发现烂瓜的细节,但她错误引用了细菌的编号;而且后来实验室另一位专家肯尼斯·雷珀(Kenneth B. Raper)还把功劳归功于一位当地妇女,是她为实验室送来了这颗烂瓜。所以究竟是谁是真正的 Moldy Mary,仍是个未解的问题。
 左图:道格拉斯·戈斯莱恩的油画作品(1948年),描绘了美国科学家玛丽·亨特在市场上检查一个哈密瓜以寻找合适的青霉菌株。右图:一个发霉的哈密瓜,上面藏着无数人的救命稻草。| 图源:Science History Institute, AdobeStock
左图:道格拉斯·戈斯莱恩的油画作品(1948年),描绘了美国科学家玛丽·亨特在市场上检查一个哈密瓜以寻找合适的青霉菌株。右图:一个发霉的哈密瓜,上面藏着无数人的救命稻草。| 图源:Science History Institute, AdobeStock最后的推手:第二次世界大战
在自己的好朋友希特利在实验室里废寝忘食做研究的同时,弗洛里也没闲着,他走访了很多美国的制药巨头,试图引起他们对青霉素生产的兴趣。
当时美国有三家公司(默克、斯奎布和礼来)实际上在弗洛里到来之前就已经进行了一些青霉素的早期研究,辉瑞公司也准备做一些相关的研究计划。但是资本毕竟是逐利的,青霉素有限的实验结果以及量产的巨大困难,让制药公司看不到这其中的利益潜力,并不愿意倾注太多的心血在其中。
弗洛里自然是不甘心,为了让青霉素作为药物尽快进行临床试验,工业量产的进程必须提到优先位置上。
学术界的人脉又一次展现了威力,弗洛里为了“搬救兵”,拜访了他在宾夕法尼亚大学的老朋友阿尔弗雷德·牛顿·理查兹教授(Alfred Newton Richards),也是当时大学医学事务的二把手。
更重要的是,理查兹是美国科学研究与发展办公室(Office of Scientific Research and Development,简称 OSRD,是美国联邦政府的一个机构,旨在二战期间进行军事目的的科学研究)下属的医学研究委员会(CMR)的主席。一方面,理查兹在学术上非常尊敬弗洛里,完全信任他对青霉素潜在价值的专业判断。另一方面,在二战背景下,他敏锐地看到了青霉素在军用领域的巨大医疗潜力。
以美国政府的名义,理查兹重新接触了让弗洛里受挫的这四家制药企业(默克、斯奎布、礼来和辉瑞),并告知他们,若他们承担青霉素生产工作,就是在服务于国家利益,那就有可能获得联邦政府的支持。聚集美国制药界的一些掌舵人物几番开会之后,医药巨头逐渐相信了青霉素的潜在价值,倍感振奋,终于开始建厂尝试实现量产。
 人类历史上首批量产青霉素其中的一支。| 图源:Mayo Clinic
人类历史上首批量产青霉素其中的一支。| 图源:Mayo Clinic朝种暮获,希特利和弗洛里的不懈努力迅速获得了成果。到 1942 年 3 月,在 OSRD 的支持下,制药企业已经生产了足够的青霉素来完整地治疗第一位感染患者;到 1942 年 6 月,又有十例病例接受了治疗。
青霉素拥有强大能力,陆续被证实对各种感染的治疗有效,包括链球菌、葡萄球菌和淋球菌感染;与此同时,美国民间和军方也都确立了青霉素在手术和伤口感染治疗中的价值。
在那之前,战争中的多数死亡并不是单纯由于外伤直接导致的,而是无法控制的感染。在第一次世界大战中,由细菌性肺炎导致的死亡率为 18%;而在前线上广泛应用了青霉素的第二次世界大战中,细菌性肺炎的死亡率迅速下降到不足 1%。
青霉素成为了二战期间拯救无数伤员生命的关键因素,堪称比枪炮更有威力的“秘密武器”。
1945 年,弗莱明、弗洛里和他的学生查恩因对青霉素的研究而获得了诺贝尔医学奖。在获奖演讲中,弗莱明说,如果不是他培养皿的意外污染,兜兜转转找到了美国的实验室,实验室研究员玛丽·亨特偶然发现了那只发霉的哈密瓜,青霉素的研究碰巧迎合了战争爆发的需求实现量产这些巧合碰撞在一起,人们或许无法享受到这一医学奇迹。
 1945年的诺贝尔生理与医学奖获奖者。| 来源:Bio Based Press
1945年的诺贝尔生理与医学奖获奖者。| 来源:Bio Based Press青霉素的耐药性:
与研发并行的达摩克斯之剑
在弗莱明那个被污染的细菌培养皿中,在霉菌团周围出现了“细菌死亡带”,似乎离霉菌近的细菌都脆弱地被杀死了。而事实上,另一场战争也在悄然发生——对青霉素耐药的“超级细菌”正在其中孕育。
在 1945 年诺贝尔生理与医学奖的获奖演讲中,弗莱明不无担忧地警告大家,抗生素虽好,但千万不要滥用,因为细菌对抗生素的耐药性已经开始显现。所谓“耐药性”,是指细菌对抗生素的杀灭(杀菌)或生长抑制(抑菌)作用失去敏感性的现象,当感染中的主要菌株对某种抗生素耐药时,这种感染可能变得无法治疗,后果严重。
青霉素在实现量产后,在全球范围大面积铺开使用。1949 年,美国青霉素的年产量已经超过了 130 万亿单位,在当时的情况足以治疗至少一亿人次的感染,价格也从 1943 年的每十万单位 20 美元降到不足 10 美分。
然而在同一时期,耐青霉素的金黄色葡萄球菌开始大范围传播,这促使科学家研发出甲氧西林等替代药物。然而,到了 1950 年以后,对甲氧西林耐药的“超级细菌”——耐甲氧西林金黄色葡萄球菌(MRSA)在世界上首次亮相,其临床治疗至今仍可谓棘手,可选药物有限。
抗生素可能会杀死在病人身上引起疾病的绝大多数细菌,但一些基因上对药物作用相对不那么敏感的细菌会存活下来。这些细菌会继续繁殖,或者通过基因交换的过程将其耐药性传递给同种的其他细菌。由于抗生素杀死或减少了它们更容易受损的竞争者,这些耐药菌株得以大量繁殖。最终结果是,人类中出现了对一种甚至几种抗生素无法治愈的细菌感染。抗生素的任意和不精确使用促进了这种细菌耐药性的传播。
进入 21 世纪,耐药性问题愈发严峻,已经成为全球性的重大公共卫生威胁。如今,耐药菌株不仅局限于医院环境,还在社区中传播,甚至出现对多种抗生素都耐药的“泛耐药菌”,如耐碳青霉烯类肠杆菌(CRE),现有抗生素几乎无药可治。2024 年 9 月发表在《柳叶刀》上的一项统计研究显示,在 1990 年至 2021 年间,平均每年有整整一百万人死于耐药菌感染,而这一数字到 2050 年将会翻倍到每年二百万人。照这样预估下去,2050 年全球累计会有接近四千万人因耐药菌感染失去生命,这个恐怖的数字,直追 1918 年大流感的致死人数。
这似乎是一个悖论:抗生素救人越多,耐药的病菌害人就越深。在感染治疗的领域中,下一片照亮前路的曙光,又在哪呢?
也许正如青霉素发现的历程一样,某种能克服细菌耐药性的方法,在历史时间线的某一点等待着人类去偶遇。但是,我们更应该向百年前为了青霉素的研发和推广而奔走相告的科学家们看齐,铭记他们在一些偶然事件背后、那些必然的付出和坚持,是这些,才得以让一个又一个的巧合,串联为科学史中的传奇。
 青霉素发现者亚历山大·弗莱明的墓志铭。| 图源:CEphoto, Uwe Aranas
青霉素发现者亚历山大·弗莱明的墓志铭。| 图源:CEphoto, Uwe Aranas小提示:
看到这里,是不是觉得自己冰箱里那颗发霉的哈密瓜或许也可以用于人类伟大的研究中?千万不要这样想,更不要想着去网上售卖给研究人员。
正规的实验耗材有供应商,研究人员一般不会从网购平台采购。因此,家中如有发霉的食物,应尽快处理掉,否则还可能给自己带来安全隐患。对于一些免疫力较低的人群,仅仅是吸入霉菌孢子就可能会导致肺部感染。
参考文献
[1]https://en.wikipedia.org/wiki/Alexander_Fleming
[2]https://www.nature.com/articles/ja201762
[3]https://sangerinstitute.blog/2019/06/06/breaking-the-mould-the-story-of-penicillin/
[4]https://www.acs.org/education/whatischemistry/landmarks/flemingpenicillin.html
[5]https://pmc.ncbi.nlm.nih.gov/articles/PMC5403050/
[6]https://www.healio.com/news/endocrinology/20120325/penicillin-an-accidental-discovery-changed-the-course-of-medicine
[7]https://www.sciencehistory.org/stories/disappearing-pod/the-forgotten-mother-of-penicillin/
[8]https://www.sciencehistory.org/stories/disappearing-pod/the-forgotten-mother-of-penicillin/
[9]https://www.pbs.org/newshour/health/the-real-story-behind-the-worlds-first-antibiotic
[10]https://www.nature.com/articles/d41586-024-03033-w
[11]https://www.thelancet.com/action/showPdf?pii=S0140-6736%2824%2901867-1
策划制作
原标题:《菜市场里的一颗发霉哈密瓜,竟然藏着千万人的“救命稻草”......》

